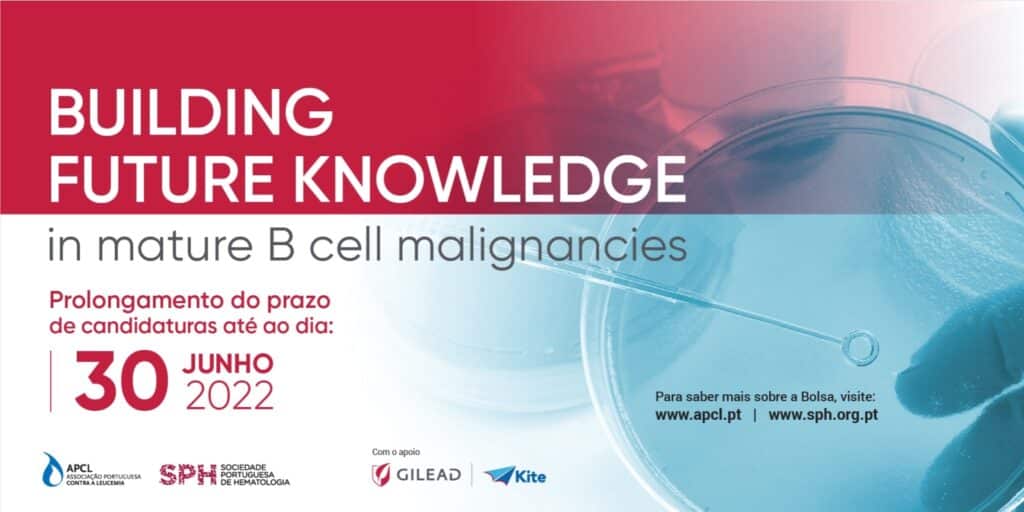

O prazo de candidaturas à 4.ª edição da bolsa “Building Future Knowledge in mature B cell malignacies” foi alargado até 30 de junho. Esta é uma iniciativa da Associação Portuguesa Contra a Leucemia (APCL), em parceria com a Sociedade Portuguesa de Hematologia (SPH) e com o apoio da biofarmacêutica Gilead Sciences, que visa promover a investigação científica e epidemiológica nas áreas das neoplasias de células B maduras, distinguindo o projeto de investigação mais promissor com 15 mil euros.
Todos os investigadores, nacionais ou estrangeiros, que estejam a desenvolver projetos em instituições portuguesas na área de investigação científica e/ou epidemiológica em neoplasias B de células maduras podem candidatar-se à bolsa. Serão valorizados projetos de carácter interdisciplinar e de colaboração entre instituições, com foco no estudo das áreas de tratamento, diagnóstico, epidemiologia, qualidade de vida dos doentes e impacto a nível sociológico.
As candidaturas devem ser enviadas para o email bolsas@apcl.pt até à nova data limite, 30 de junho. Para saber mais consulte o regulamento no site da APCL, aqui: https://www.apcl.pt/pt/novidades/bolsa-building-future-knowledge-in-mature-b-cell-malignancies-27-05-2022.






